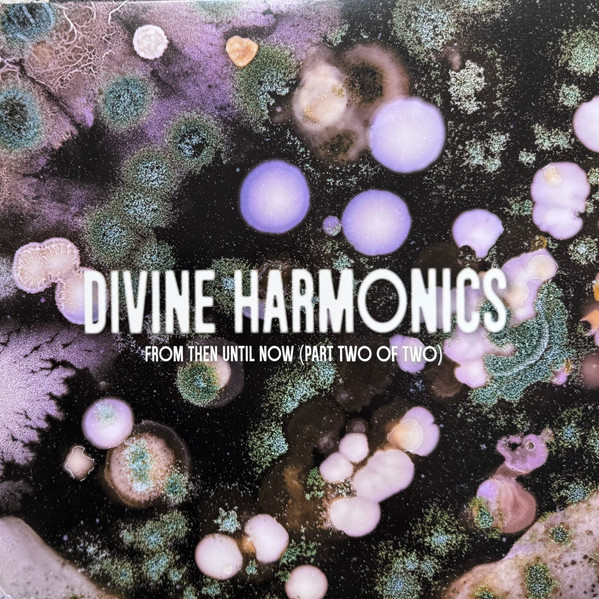
Kuniyuki Takahashi , Joe Claussell - Divine Harmonics - From Then Until Now (Part Two Of Two) | SORA (SORA 003PT2)

By continuing your navigation on this website, you accept the use of cookies for statistical purposes.




Kuniyuki Takahashi, Joe Claussell
When We Are All Truly Free / I Believe
A
Kuniyuki Takahashi - When We Are All Truly Free (The Cosmic Arts Ambient Suite)
B
Joe Claussell - I Believe (Demo Test Composition Dub)